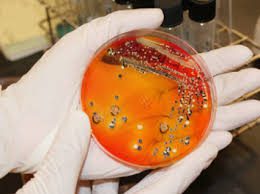

Що потрібно знати про сальмонельоз, щоб вберегти себе від лікарняного ліжка розповість iluchanyn за інформацією МОЗ .
За останніх 6 місяців на Волині трапилося декілька спалахів сальмонельозу. Останній був у Ківерцях, де люди потрапили до лікарні після поминального обіду.
Що таке сальмонельоз?
Сальмонельоз – це гостре інфекційне захворювання, яке вражає шлунково-кишковий тракт та інші органи.
Збудником цієї інфекції є бактерія Salmonella. Вона переважно вражає травну сист
Як проявляє себе?
В перші години зараження людина може відчувати легке занедужання, здуття живота, температура, запаморочення, біль у скронях.
На другу добу з’являється біль в животі, блювота(зелена та водяниста), діарея з обезводненням організму.
Інкубаційний період – від 12 год до 3 діб.
Триває захворювання від 3 діб до 2 тижнів.
Звідки береться сальмонельоз?
Джерелом розповсюдження бактерії є: велика рогата худоба, свині, кури, водоплавна птиця, різні гризуни.
У більшості випадків ці тварини інфікуються через комбікорм, в склад якого входить перероблена тваринна сировина та не дотримані мікрокліматичні норми в приміщенні(дуже спекотно).
Де можна заразитися?
Найчастіше підчепити інфекцію можна через продукти харчування:
- 1.В суспільстві існує думка, що основним продуктом зараження є курячі яйця. Проте інфекціоністи спростовують цей міф: у свіжих яйцях сальмонели немає. Однак частинки посліду курки, можуть потрапити на шкаралупу. Вже тоді бактерії проникають всередину яйця і інфікують його.
- Порушення режиму обробки риби, м’ясних та молочних продуктів теж може бути причиною захворювання сальмонельозом.
- Слід зауважити, що заразитися можна і через кухонний інвентар.
- Буває й таке, що інфікування проходить від людини-носія сальмонели.
- Вода і лід невпорядкованих водойм теж можуть стати зараженням їжі.
Як лікуватися?
Оскільки, сальмонельоз – дуже важке інфекційне захворювання, то слід негайно звернутися до лікарів. Якщо згаяти час – вона може перейти в хронічну форму.
Важливо знати, що більшість збудників кишкових інфекцій стійкі до антибіотиків, тому не варто займатись самолікуванням. Не можна забувати, що заражена сальмонелою людина є небезпечною для інших.
Як вберегти себе від сальмонельозу?
Для того, щоб не стати жертвою сальмонельозу важливо пам’ятати головний факт – сальмонела гине після термічної обробки. Тому потрібно:
- мити руки з милом перед приготуванням їжі;
- мити та обдавати окропом овочі та фрукти;
- вживати бутильовану або кип’ячену воду;
- всі м’ясні, рибні страви та яйця слід піддавати правильній термічній обробці;
- окропом обдати кухонний інвентар, яким нарізали рибу чи м’ясо;
- уникати контакту хлібобулочних виробів з немитими овочами чи фруктами.
А якщо зараження відбулося в закладі громадського харчування?
Вберегти себе від інфікування сальмонелою в ресторані, піцерії чи іншому закладі громадського харчування майже неможливо. Ця відповідальність лежить на добросовісному виконанні своїх обов’язків працівників закладу, а також на Держспоживслужбі, яка до слова, нещодавно змінила правила перевірки. Відтепер інспектори органу контролю перевірятимуть заклади без попередження та в залежності від ступеня ризику для життя і здоров’я людей.
Чи достатньо цього?Вирішуйте самі.
Кожен відвідувач повинен знати:
- Завжди забирайте чек. Саме він потім може стати доказом того, що саме ця їжа була причиною отруєння.
- Засвідчіть факт отруєння в лікаря.
- Зверніться до адміністрації закладу.
Бережіть своє здоров’я та пам’ятайте, факт отруєння краще попередити, ніж доводити.